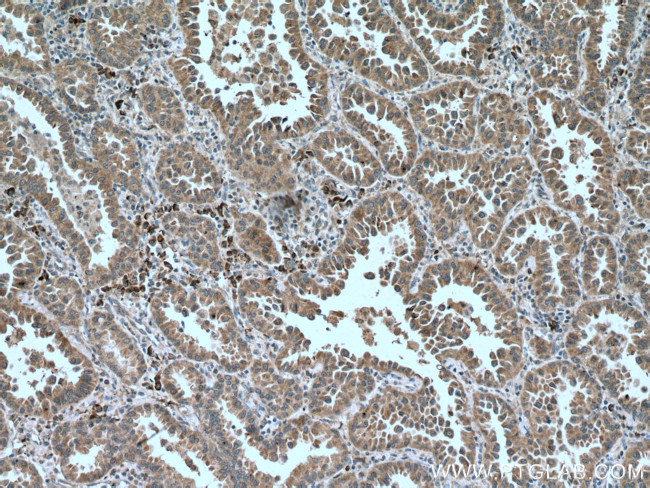
PHEX Antibody in Immunohistochemistry (Paraffin) (IHC (P))

Search
Proteintech
PHEX Monoclonal Antibody (1D4B2)
{{$productOrderCtrl.translations['antibody.pdp.commerceCard.promotion.promotions']}}
{{$productOrderCtrl.translations['antibody.pdp.commerceCard.promotion.viewpromo']}}
{{$productOrderCtrl.translations['antibody.pdp.commerceCard.promotion.promocode']}}: {{promo.promoCode}} {{promo.promoTitle}} {{promo.promoDescription}}. {{$productOrderCtrl.translations['antibody.pdp.commerceCard.promotion.learnmore']}}
产品信息
66934-1-IG
种属反应
宿主/亚型
分类
类型
克隆号
抗原
偶联物
形式
浓度
纯化类型
保存液
内含物
保存条件
运输条件
产品详细信息
Aliquoting is unnecessary for -20°C storage.
靶标信息
Peptidase that cleaves SIBLING (small integrin-binding ligand, N-linked glycoprotein)-derived ASARM peptides, thus regulating their biological activity. Cleaves ASARM peptides between Ser and Glu or Asp residues. Regulates osteogenic cell differentiation and bone mineralization through the cleavage of the MEPE-derived ASARM peptide. Promotes dentin mineralization and renal phosphate reabsorption by cleaving DMP1- and MEPE-derived ASARM peptides. Inhibits the cleavage of MEPE by CTSB/cathepsin B thus preventing MEPE degradation.
仅用于科研。不用于诊断过程。未经明确授权不得转售。
生物信息学
蛋白别名: HYP; Metalloendopeptidase homolog PEX; phosphate regulating gene with homologies to endopeptidases on the X chromosome (hypophosphatemia, vitamin D resistant rickets); Phosphate regulating neutral endopeptidase on the X chromosome (X-linked hypophosphatemia XLH); phosphate-regulating neutral endopeptidase; Phosphate-regulating neutral endopeptidase PHEX; Vitamin D-resistant hypophosphatemic rickets protein; X-linked hypophosphatemia protein
基因别名: HPDR; HPDR1; HYP; HYP1; LXHR; PEX; PHEX; XLH
UniProt ID: (Human) P78562
Entrez Gene ID: (Pig) 100154258, (Human) 5251, (Rat) 25512